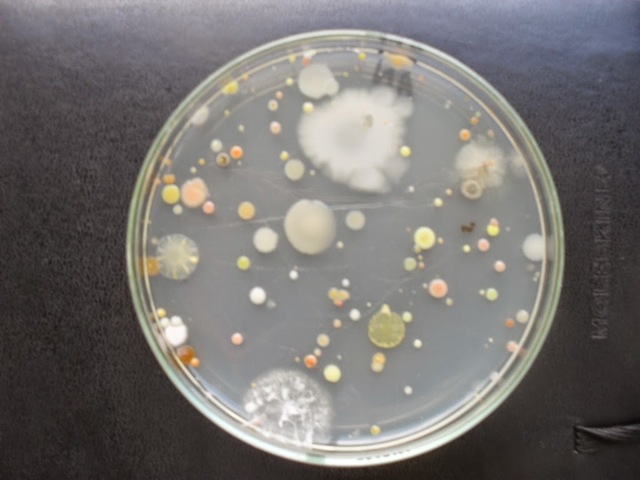
Crecimiento de bacterias en medios sólidos
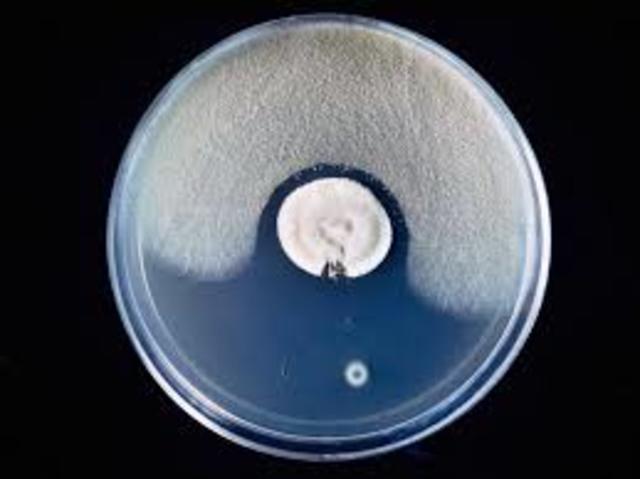
Descubrimiento de la antibiosis.

-
Girolamo Frascatoro estudia enfermedades contagiosas y propone una teoría sobre su origen.
-
Hans Janssen desarrolla el primer microscopio compuesto.
-
Francesco Redi fue el primero en refutar la teoría de la generación espontánea en gusanos.
-
Anton van Leeuwenhoek es el primero en observar bacterias o "animálculos".
-
Antony van Leeuwenhoek describe las primeras observaciones realizadas con microscopios caseros de los microorganismos (llamados entonces animáculos) presentes en agua de lluvia, fuentes, mar y nieve así como de muestras tomadas de materia interdental.
-
Anton van En 1677 menciona por primera vez los espermatozoides en una carta enviada a la Royal Society, en la que habla de animálculos muy numerosos en el esperma
-
Edward Jenner desarrolla la primera vacuna contra la viruela humana.
-
Jenner tomó linfa de una pústula de viruela bovina formada en la muñeca de una trabajadora de lechería llamada Sarah Nelmes y la insertó en dos incisiones superficiales hechas en los brazos de un niño, James Phipps. Así describe su evolución:
-
Theodore Schwann realiza los primeros experimentos relacionados con la fermentación y la putrefacción originados por microorganismos.
-
John Snow realiza el primer estudio epidemiológico del cólera en Londres.
-
En1857 Louis Pasteur demuestra que las infecciones están relacionadas con los microorganismos, que se pueden cultivar y, por lo tanto, estudiar.
-
Joseph Lister desarrolla el principio de la asepsia en la práctica quirúrgica.
-
Obermeier, encuentra por primera vez una bacteria, Borrelia, en la sangre de un enfermo de fiebres recurrentes.
-
El cientifico Robert korch en 1881 tenía inventados los métodos sobre medio sólido para obtener cultivos bacterianos puros. Cuando Koch mostró sus cultivos puros en el Congreso Internacional de Londres, Pasteur exclamó: ¡Es un enorme progreso!. Por lo demás, Pasteur probablemente no había estado trabajando con cultivos puros.
-
Robert korch descubrió el Mycobacterium tuberculosis y formuló los postulados -que llevan su nombre- para demostrar el origen bacteriano de una enfermedad:
-
Louis Pasteur habia creado la vacuna contra la rabia y en 1884 aplica su tratamiento al joven Joseph Meister, quien había estado expuesto al virus de la rabia, y lo salva. Sólo en los 15 meses siguientes más de 2.500 víctimas de mordeduras de perros rabiosos fueron tratadas de la misma manera.
-
Julius Richard inventó las denominadas placas de Petri, unos recipientes circulares inicialmente de vidrio (actualmente de plástico) de unos diez centímetros de diámetro y un centímetro de alto, utilizados para albergar los medios de cultivo utilizados en bacteriología
-
Walter Reed confirma que la fiebre amarilla es transmitida por mosquitos, hecho previamente observado por Carlos Finlay en 1881
-
Howard Taylor Ricketts demuestra que la fiebre de las Montañas Rocosas es transmitida por garrapatas, y aisló el microorganismo causante de la enfermedad (que él llamó rickettsia). Falleció por esa enfermedad.
-
Paul Ehrlich descubre el salvarsán (balas mágicas), primer agente quimioterapéutico contra la sífilis.
-
Francis Peyton Rous descubre el virus (retrovirus) que produce tumores (sarcomas) en pollos.
-
Frederick Twort descubre los virus que infectan bacterias (bacteriófagos).
-
Fue creada por Alexander Fleming, El descubrimiento de la penicilina ha sido presentado como un ejemplo «icónico» de cómo procede el método científico a través de la observación, y de la habilidad singular de Alexander Fleming interpretando un fenómeno casual.
-
Fleming descubre el fenómeno de la antibiosis.
-
Alfred Hershey y Martha Chase demuestran que el DNA era el material genético de algunos virus.
-
Esta teoria propuesta por M. Burnet establece que el antígeno, al ingresar al organismo, selecciona a un clon linfocitario preexistente y específico para él induciendo su expansión.
-
los cientificos Francois Jacob, David Perrin, Carmen Sánchez y Jaques Monod propusieron el termino operon lo cual es un mecanismo que controla a los genes aunque mas tarde se descubriera que era un proceso mas complicado, pero sin embargo fue un paso crucial para conocer a fondo el proceso de como operan los genes.
-
Marshall Nirenberg y Matthaei descubren que el codón UUU codificaba para el aminoácido fenilalanina, experimento que sentó las bases para la elucidación del código genético.
-
Robert W. Holley aísla los tRNA, moléculas que incorporan los aminoácidos activados en las proteínas.
-
Werner Arber, Daniel Nathans y Hamilton Smith descubren los enzimas de restricción, herramientas esenciales para el desarrollo de la Ingeniería Genética.
-
Bruce Ames crea un test bacteriano para detectar mutágenos y carcinógenos
-
En Filadelfia (Estados Unidos) aparece la enfermedad de los legionarios.
-
Woese y George E. Fox reconocen las archeas como el tercer dominio de los seres vivos
-
Último caso de viruela en el mundo, ocurrido en forma natural, en Somalia. 3 años después fue declarada erradicada totalmente del mundo (1º enfermedad en conseguir este galardón)
-
Robert Gallo y Luc Montagnier llevan a cabo el aislamiento e identificación del virus del sida.
-
Hopwood y col. realizaron la secuenciación del genoma de Streptomyces coelicolor.
-
Aparece en China la neumonía atípica (síndrome respiratorio agudo, SARS), enfermedad respiratoria producida por un coronavirus.
-
Aparece en Asia la gripe aviar, producida por el subtipo H5N1 del virus Influenza A que puede transmitirse al hombre.
-
México aparece un brote de gripe porcina, posteriormente llamada gripe A H1N1
-
Prusiner descubre los priones, agentes causantes de la encefalopatía espongiforme bovina y de la enfermedad de Creutzfeldt-Jakob.
A list shows items. A timeline shows sequence.
Use Timetoast to make dates, milestones, and turning points easier to understand in a clear visual format. Timetoast is a timeline maker for work, school, research, and stories.